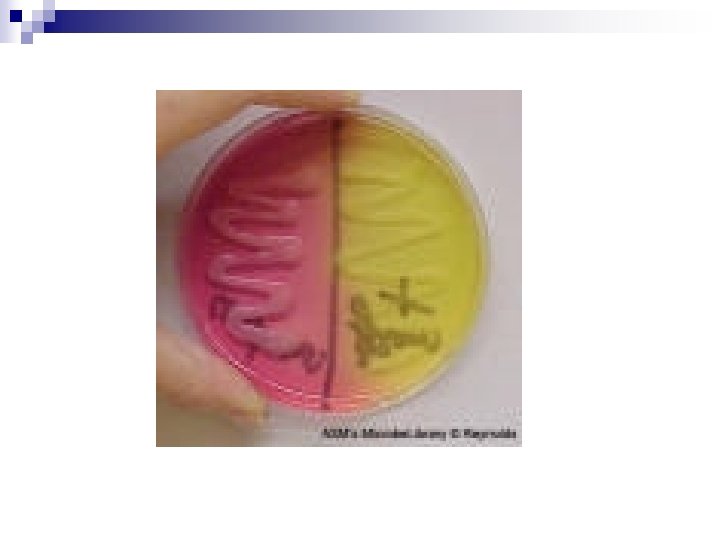
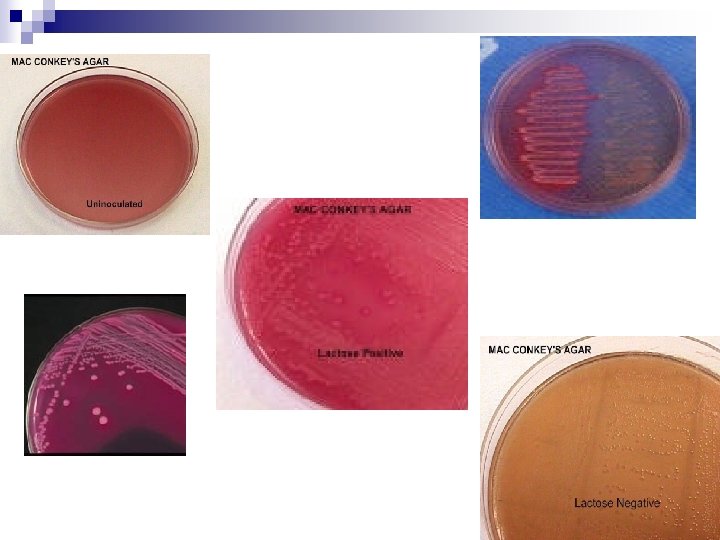

Lab 13 Bacterial cultivation Selective differential media Lab

Lab 13 Bacterial cultivation Selective /differential media

Lab activities: Demo selective and differentiation plates n Streaking bacteria on differentiation plates n

Cultivation n The process of growing microorganisms in culture by taking bacteria from the infection site (in vivo or environment) and grow them in artificial environment in the laboratory (in vitro).

Growth needs n Fastidious bacteria – relatively complex growth needs n Non-fastidious bacteria- relatively basic and straightforward growth needs

Phases of growth media n Broth- Growth of bacteria will change the liquid from clear to turbid (cloudy). n Solid – Agar plates, slants – Bacterial cells inoculated on solid media will multiply enough to be seen by naked eye.

Colony- (clone) n Colony- A bacterial population derived from one bacterial cell. The cells within the colony have identical, genus, species, genetic and phenotypic characteristics. n Pure bacteria - derived from a single colony. n Selection of a pure colony -most important for bacterial identification

Media classification and function n Enrichment – Used to enhance growth of a particular pathogen n Supportive - support growth of most non fastidious bacteria

Media classification and function n Selective - Contain inhibitory agents that are inhibitory to all organisms except those sought n Differential - Contain factors that allow bacterial species to manifest certain metabolic characteristics that distinguish them from other species. n Media can be both selective and differential based on the ingredients of the medium.

Blood agar plate (BA) n Nutrient agar with 5% sheep blood n Cultivation of fastidious and non fastidious bacteria. n Differential – Identify hemolysis - Some bacteria secrete enzymes that lyse red blood cells (hemolysins) such that a clearing around the colony appears. ¨b hemolysis- complete clearing (white hemolysis) ¨a hemolysis – incomplete clearing (green hemolysis) ¨g hemolysis- no hemolysis



Mannitol Salt Agar (MSA) n Both selective and differential medium. n High salt concentration - inhibits most bacteria. n Selective for Staphylococcus sp. n Differentiate between Staphylococcus sp. by the sugar mannitol fermentation. n Mannitol fermention produce acids that change the medium p. H. n n Peach color- neutral- no fermentation Bright yellow- Acidic – mannitol fermentation (Staph. coag. pos. - Staph. aureus)

Mac. Conkey Agar (MAC) n Selective and differential medium. n Selective - Gram positive bacteria are inhibited by the presence of bile salts and crystal violet inhibitors in the medium Most of gram negative bacteria will grow. n Differentiate- Between Gram negative bacteria by their ability to ferment lactose. n Pink colonies- Bacteria that ferment lactose (precipitation of some salts in media by acid production). n Pale colonies- Non fermenters

Eosine Methylene blue (EMB), n Differentiatial between lactose fermenting and non fermenting enteric bacteria

Tellurite Glycine Agar (TGA) n Selective- Tellurite glycine and lithium inhibit most bacteria n Preferential growth of Staphyloccoci coagulase positive (Staphyloccocus aureus)

Bacteria streaked in lab n n Staphylococcus aureus Staphylococcus epidermidis Salmonella pullorum, E. coli S. aureus S. pullurum S. epidermidis E. coli EMB and TGA
- Slides: 18